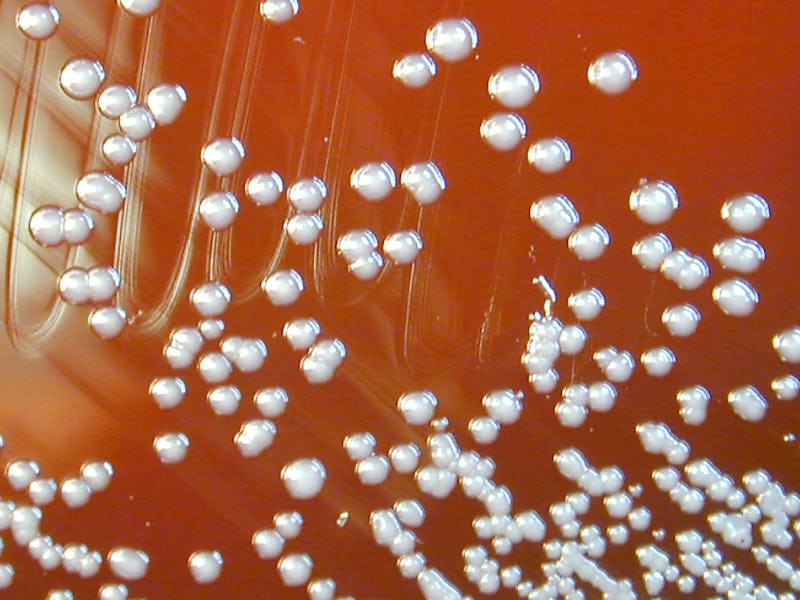

A deadly disease-causing bacteria was detected in US soil samples — here's what you need to know
The bacteria can cause a rare but serious disease called melioidosis.
This week, the Centers for Disease Control issued a health advisory about a potentially deadly bacteria found in the soil of the Gulf Coast region of Southern Mississippi. The microbe, Burkholderia pseudomallei, isn’t novel. Its endemic in some tropical and subtropical climates like Southeast Asia and Northern Australia but its recent detection in the Gulf is the first time the bacteria has been detected in water and soil samples in the continental United States.
B. pseudomallei can cause melioidosis, two cases of which have been detected in the Gulf region in as many years: one in 2020 and one in 2022. Soil samples indicate the bacteria has been present since at least 2020 and genomic sequencing “revealed the two patients were infected by the same novel strain from the Western Hemisphere,” according to the CDC advisory.
The disease is relatively rare, however, and the majority of the time, an infection with the bacterium will not result in the disease. A 2008 study of Thai children found that only one of every 4600 exposures to the bacteria results in melioidosis.
According to a 2019 study, in Southeast Asia, where the bacteria is endemic, “the in-hospital mortality rate exceeds 40 percent.” Fortunately, however, the risk of person-to-person spread of melioidosis is low and the CDC says, “there are few documented cases of person to person transmission; contact between damaged (non-intact) skin and contaminated soil or water is the most frequent route for natural infection.”
Norman Beatty, an Assistant Professor of Medicine at the University of Florida College of Medicine, and infectious disease specialist tells Inverse that it was a “surprise” to learn that melioidosis was found in the Gulf.
“Melioidosis is a serious infectious disease and will now need to be considered in those living in the Gulf Coast who present with clinical concerns for this type of infection,” he says.
Here’s everything you need to know about B. pseudomallei and melioidosis.
What are the symptoms of melioidosis?
According to the CDC, melioidosis usually appears two to four weeks after exposure to B. pseudomallei, but it can appear as little as a day after or as long as a year or more following exposure. The disease can present in a wide range of symptoms, making it difficult to diagnose. The most common symptom of melioidosis is a lung infection; the CDC notes that pneumonia is found in over 50 percent of cases.
But, the disease isn’t limited to the lungs, according to Beatty.
“Infection can be found in any organ of the body,” he says. “Transmission occurs through inoculation of skin or mucous membrane, inhaled particles containing the bacteria, and also ingestion of contaminated food products.” He adds that some infections can “mimic other conditions like tuberculosis.”
When the infection is localized, it can present as localized pain or swelling, fever, ulceration, or abscess. It can also present as a pulmonary infection with cough, chest pain, high fever, and headache.
Sepsis — a dangerous infection of the bloodstream that can quickly become fatal — is also possible. In addition to high fever, symptoms of melioidosis-induced sepsis can include respiratory distress, abdominal discomfort, joint pain, and disorientation.
Finally, disseminated infection is also possible, with the infection spreading throughout the body. In addition to headache and fever, symptoms can include “weight loss, stomach or chest pain, muscle or joint pain, central nervous system/brain infection, and seizures,” the CDC writes.
Soil samples indicate Burkholderia pseudomallei has been present since at least 2020 and genomic sequencing “revealed the two patients were infected by the same novel strain from the Western Hemisphere,” according to the CDC advisory.
Melioidosis treatment generally starts with “intravenous antimicrobial therapy for a minimum of two weeks” which can extend up to eight weeks, depending on the severity of the infection. That course of treatment is then followed by three to six months of oral antimicrobial therapy.
“Early recognition and appropriate antibiotic administration has led to decreased mortality,” says Beatty.
Fortunately, both cases originating in the Gulf were successfully treated.
Who is most at risk of melioidosis?
While anyone who is exposed to B. pseudomallei can contract melioidosis, according to the CDC, underlying conditions like “diabetes, excessive alcohol use, liver disease, renal disease, thalassemia, cancer, chronic lung disease,” or other immunosuppressive conditions may increase the likelihood of developing the disease, according to the CDC’s report.
“In general, when working with soil one should wear gloves and avoid contamination of wounds,” Beatty says. “If more cases are isolated in southern Mississippi or other regions of the Gulf Coast, those with immunocompromising conditions should protect themselves from the soil or inhaling environmental particles that could be contaminated with B. Pseudomallei.”
Have there been other cases of melioidosis in the United States?
Aside from the cases originating in the Gulf, two other cases of the disease have occurred within the United States in recent years. In 2021, four cases of melioidosis were traced back to contaminated aromatherapy spray sold at Walmart. Two of the four people died.
Can B. pseudomallei be eradicated from the soil?
Unfortunately, once the bacteria becomes endemic in soil, it can’t be eradicated, the CDC’s report says. Thus, “Public health efforts should focus primarily on improving identification of cases so that appropriate treatment can be administered,” the CDC report says. The report adds that following a favorable vote at the 2022 Council of State and Territorial Epidemiologists conference, melioidosis is now a Nationally Notifiable Disease, which means public health officials will be more actively looking for and reporting instances of the disease.
“Clinicians practicing in the Gulf Coast of the U.S. should be thinking about Melioidosis among those presenting with severe pneumonia or skin infections that fail to respond to antibiotics that normally treat typical skin pathogens,” Beatty says. “With more awareness, we are likely to see more cases being identified. The COVID-19 pandemic and now monkeypox have brought attention to how infectious diseases can move around the world, but it is too soon to know if Melioidosis is a true threat.”
This article was originally published on